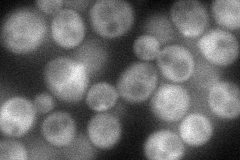
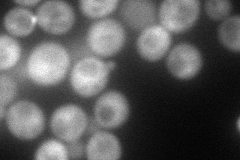
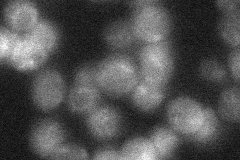
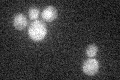

View description
Protein of unknown function, computational analysis of large-scale protein-protein interaction data suggests a possible role in actin cytoskeleton organization; potential Cdc28p substrate
Localization:
Intensity:
Fold change:
Significance:
-
C’ GFP library in SD

cytosol31.1 -
N' NOP1pr-GFP in SD
cytosol,bud neck69.9763 -
N' TEF2pr-mCherry in SD
cytosol98.5837 -
N' NATIVEpr-GFP in SD
below threshold18.7679 -
N' TEF2pr-VC and Cyto-VN in SD

cytosol47.9584 -
C’ GFP library in SD+DTT

cytosol28.470.91No -
C’ GFP library in SD+H2O2

cytosol25.210.81No -
C’ GFP library in Starvation Media
cytosol26.790.86No -
C’ GFP library on the background of Pup2-DaMP

cytosol -
C’ GFP library on the background of CCT mutant

cytosol41.11711.32185No
